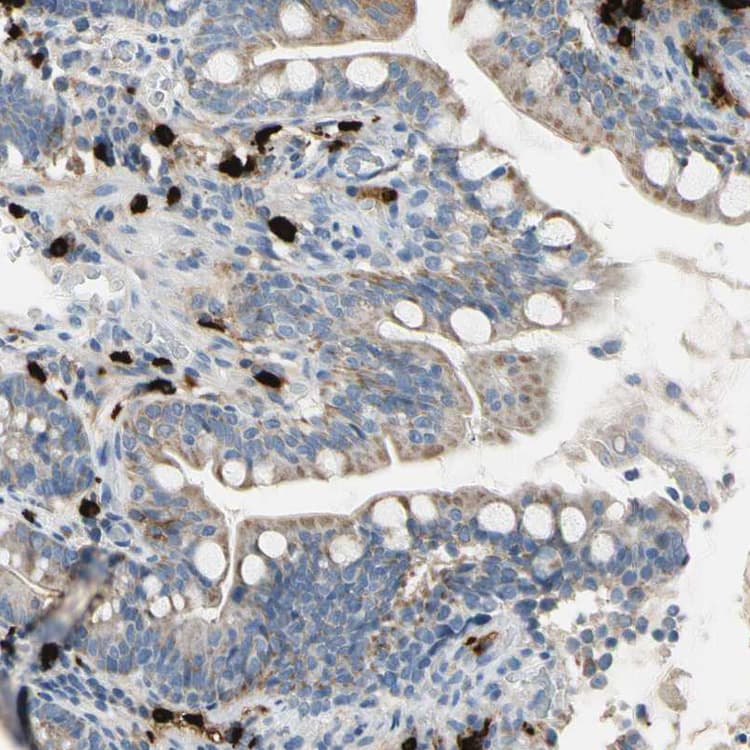

Anti-CPA3 antibody(ab251696)
$undefined

Rabbit Polyclonal CPA3 antibody. Suitable for IHC-P and reacts with Human samples. Cited in 2 publications. Immunogen corresponding to Recombinant Fragment Protein within Human Mast cell carboxypeptidase A aa 200-400.
| Shipped At Conditions | Blue Ice |
| Appropriate Long term Storage Conditions | Store at -20°C. |
| Clonality | Polyclonal |
| Applications | IHC-P |
| Species Reactivity | Human |
| Isotype | IgG |